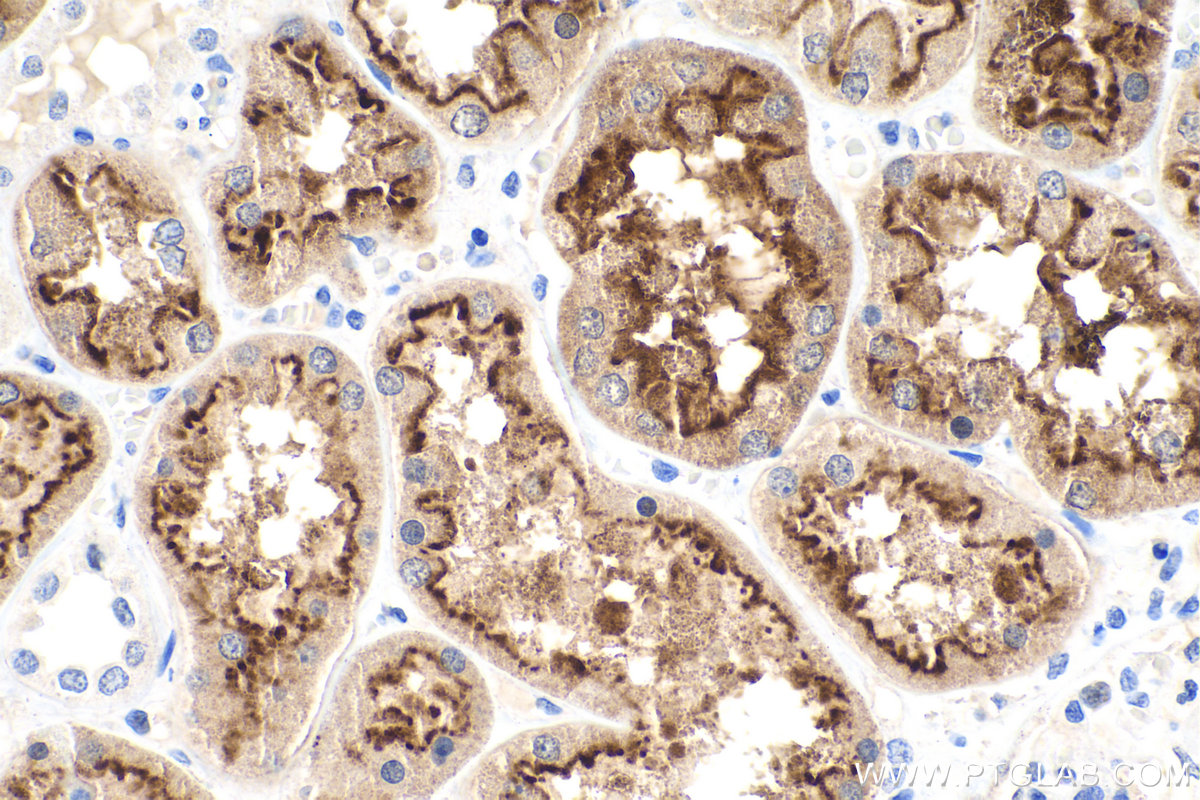

验证数据展示
经过测试的应用
| Positive WB detected in | mouse kidney tissue |
| Positive IHC detected in | human kidney tissue, mouse kidney tissue Note: suggested antigen retrieval with TE buffer pH 9.0; (*) Alternatively, antigen retrieval may be performed with citrate buffer pH 6.0 |
| Positive IF-P detected in | human kidney tissue, mouse kidney tissue |
推荐稀释比
| 应用 | 推荐稀释比 |
|---|---|
| Western Blot (WB) | WB : 1:2000-1:10000 |
| Immunohistochemistry (IHC) | IHC : 1:4000-1:16000 |
| Immunofluorescence (IF)-P | IF-P : 1:50-1:500 |
| It is recommended that this reagent should be titrated in each testing system to obtain optimal results. | |
| Sample-dependent, Check data in validation data gallery. | |
产品信息
19700-1-AP targets LRP2-Specific in WB, IHC, IF-P, ELISA applications and shows reactivity with human, mouse samples.
| 经测试应用 | WB, IHC, IF-P, ELISA Application Description |
| 文献引用应用 | WB, IHC, IF |
| 经测试反应性 | human, mouse |
| 文献引用反应性 | human, mouse, rat |
| 免疫原 |
Peptide 种属同源性预测 |
| 宿主/亚型 | Rabbit / IgG |
| 抗体类别 | Polyclonal |
| 产品类型 | Antibody |
| 全称 | low density lipoprotein-related protein 2 |
| 别名 | LRP2, DBS, Fx1a, Glycoprotein 330, gp330 |
| 计算分子量 | 522 kDa |
| 观测分子量 | 522 kDa |
| GenBank蛋白编号 | NM_004525 |
| 基因名称 | LRP2 |
| Gene ID (NCBI) | 4036 |
| RRID | AB_10640428 |
| 偶联类型 | Unconjugated |
| 形式 | Liquid |
| 纯化方式 | Antigen affinity purification |
| UNIPROT ID | P98164 |
| 储存缓冲液 | PBS with 0.02% sodium azide and 50% glycerol, pH 7.3. |
| 储存条件 | Store at -20°C. Stable for one year after shipment. Aliquoting is unnecessary for -20oC storage. |
背景介绍
LRP2, also named as gp330 and Megalin, belongs to the LDLR family. It acts together with cubilin to mediate HDL endocytosis. LRP2 may participate in regulation of parathyroid hormone and para-thyroid-hormone-related protein release. Defects in LRP2 are the cause of Donnai-Barrow syndrome (DBS).
实验方案
| Product Specific Protocols | |
|---|---|
| IF protocol for LRP2-Specific antibody 19700-1-AP | Download protocol |
| IHC protocol for LRP2-Specific antibody 19700-1-AP | Download protocol |
| WB protocol for LRP2-Specific antibody 19700-1-AP | Download protocol |
| Standard Protocols | |
|---|---|
| Click here to view our Standard Protocols |
发表文章
| Species | Application | Title |
|---|---|---|
J Hazard Mater Epigenetic reprogramming of HDAC2 in CA1 excitatory neurons determines Pb-induced non-spatial memory deficits | ||
ACS Appl Mater Interfaces Renal-Targeted Drug Delivery by Chitosan Oligosaccharide Micelles with HSA-Enriched Protein Corona for the Treatment of Ischemia/Reperfusion-Induced Acute Kidney Injury | ||
EMBO Rep Amino acid starvation-induced LDLR trafficking accelerates lipoprotein endocytosis and LDL clearance. | ||
Nephrol Dial Transplant Reduced proximal tubular expression of protein endocytic receptors in proteinuria is associated with urinary receptor shedding. | ||
Development Mouse early extra-embryonic lineages activate compensatory endocytosis in response to poor maternal nutrition. | ||
Metabolism Sodium-glucose cotransporter 2 inhibition attenuates protein overload in renal proximal tubule via suppression of megalin O-GlcNacylation in progressive diabetic nephropathy. |